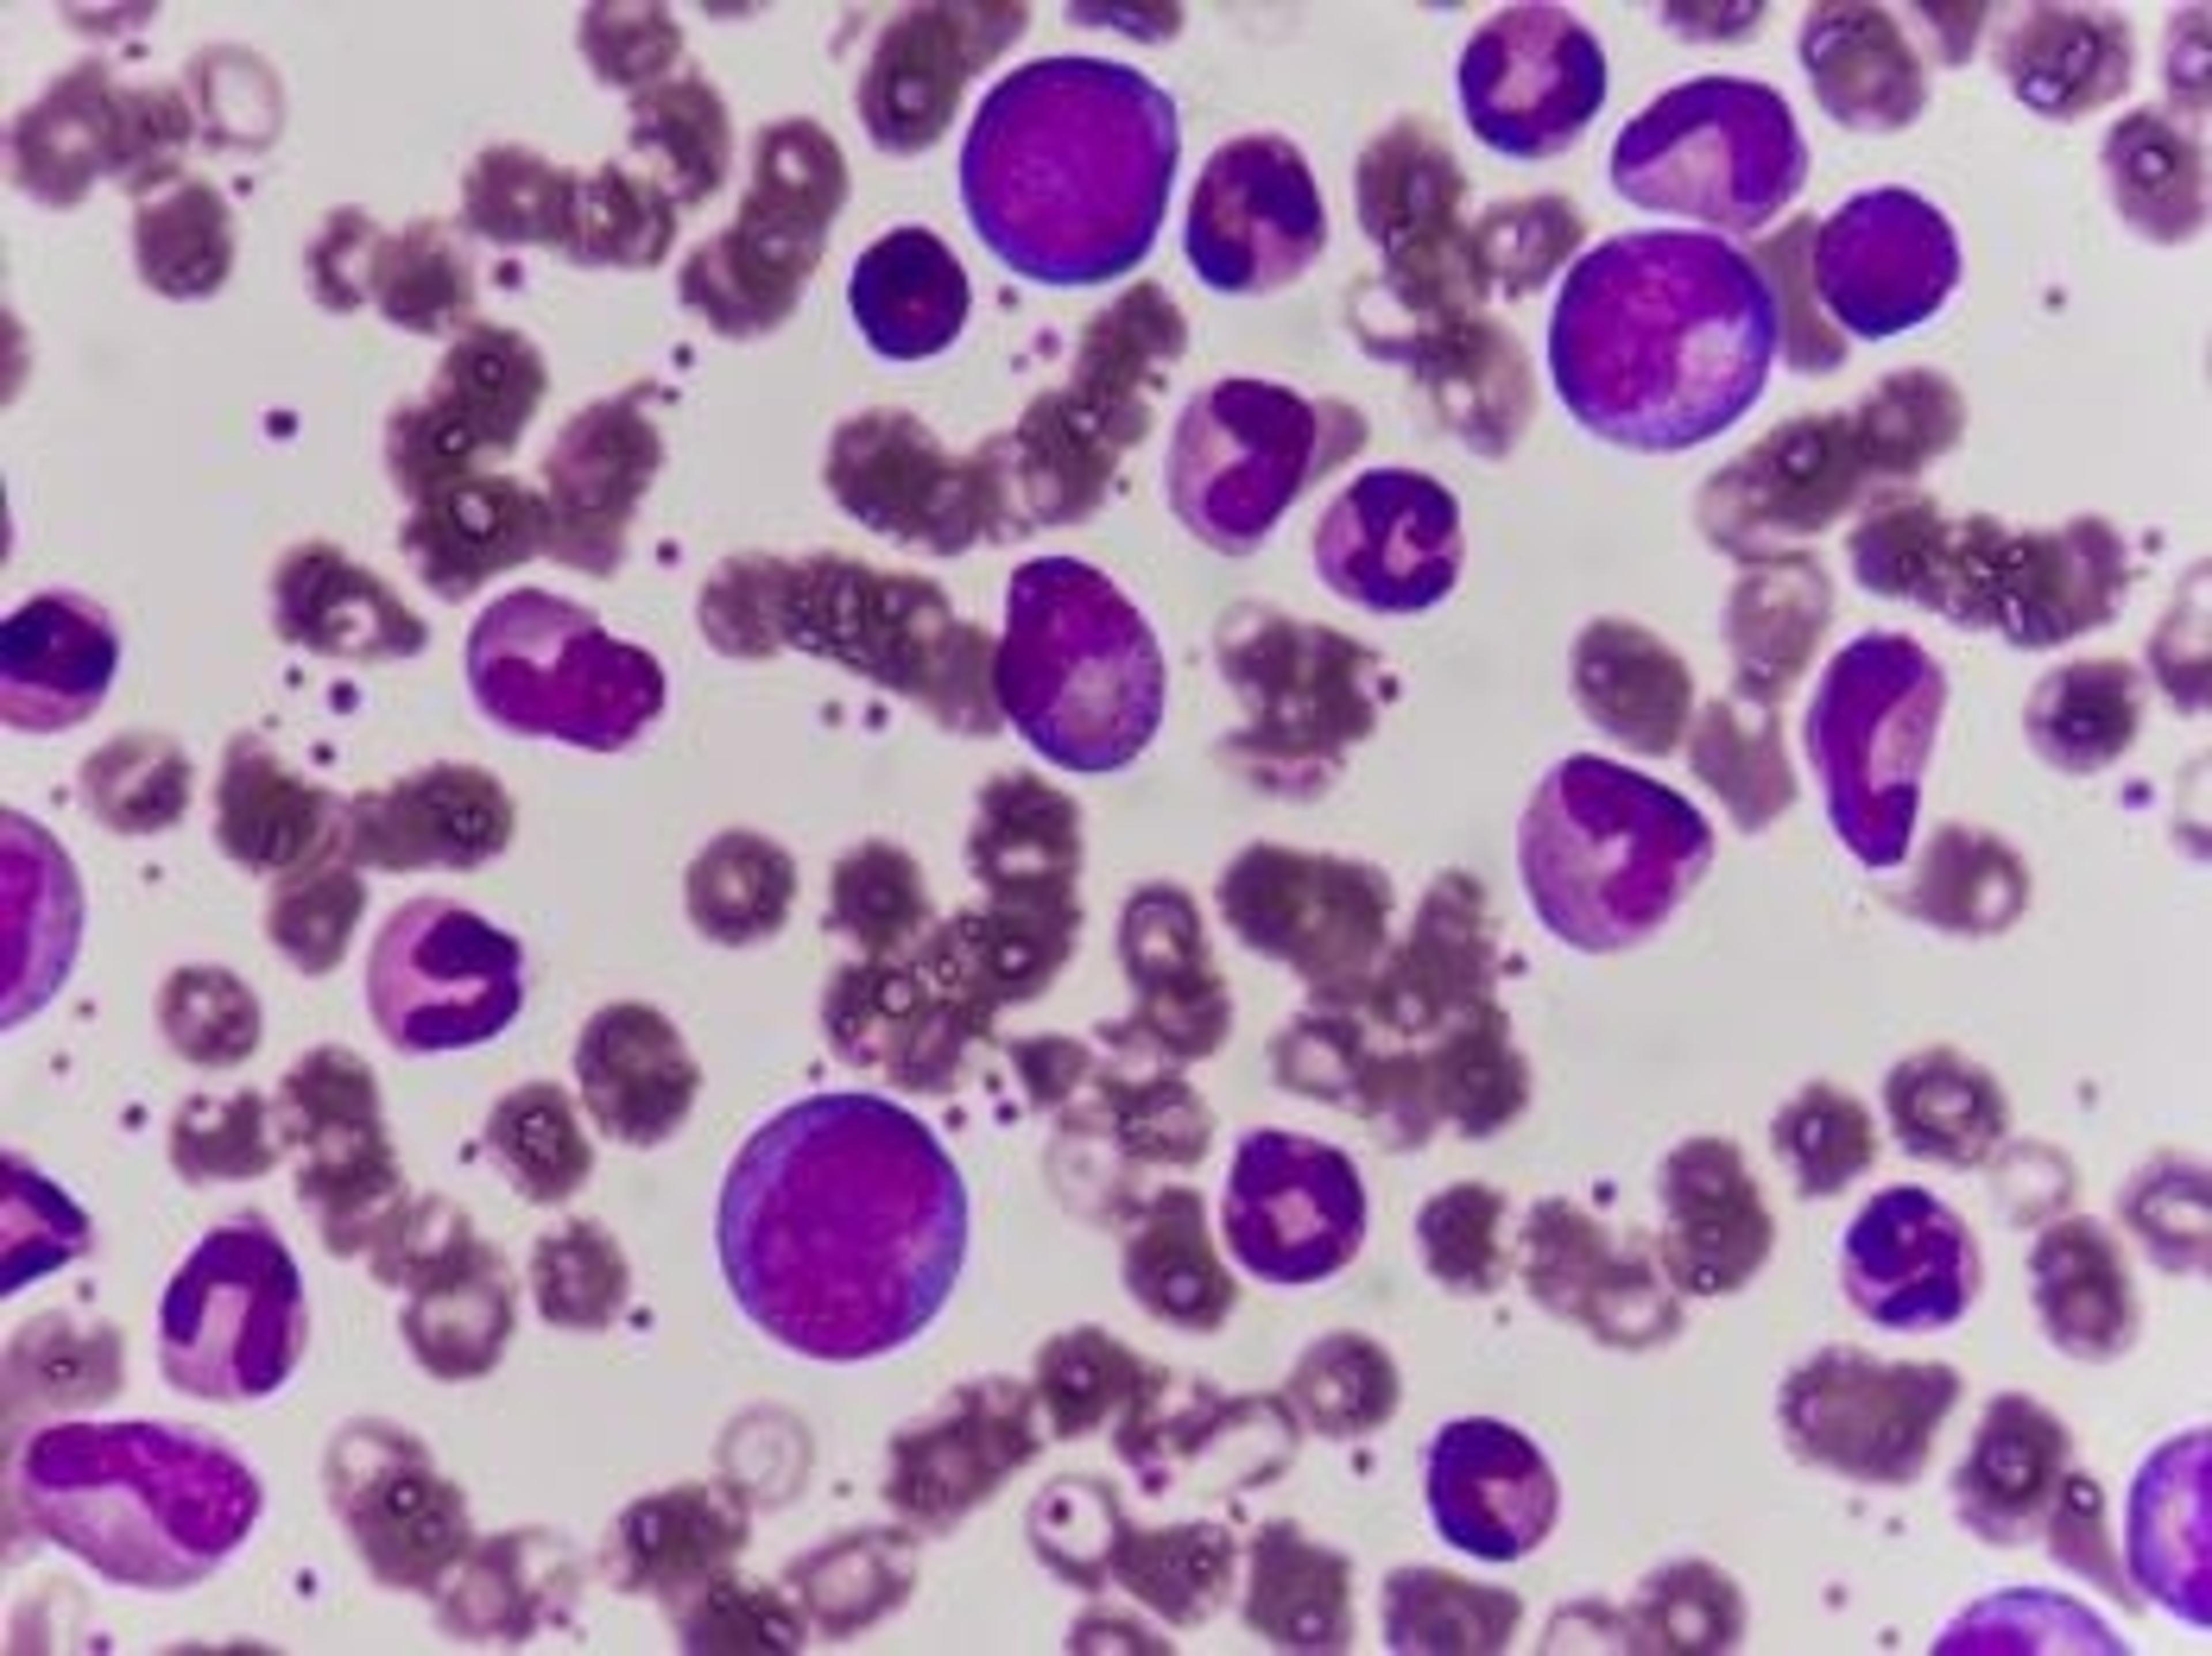

T100™ Thermal Cycler
Thermal cycler system, includes 96-well thermal cycler, power cord, tube support ring
Even if it is an old PCR machine still runs smoothly and decent results are always obtained.
Molecular biology
The simplicity and robustness of the PCR apparatus make it easy to use and guaranty always good results.
Review Date: 30 May 2025 | Bio-Rad
Great and reliable results. Vital equipment in any lab!
PCR
User interface is friendly. The PCR results are reliable. The thermalcycler even has gradient function and touch screen, which is a plus! Definitely would recommend for any new lab.
Review Date: 14 Apr 2023 | Bio-Rad
Great thermal cycler for undergrads
Amplify DNA from various samples
I am a professor that coordinates (and even teaches some of) the undergraduate biology labs at my institution. I needed to buy a thermal cycler that would stand up to student use, and be easy for them to use. This fits the bill! We have been using it regularly for a few years now and are very happy. Everything works great. The saved programs and the touchscreen are great features.
Review Date: 23 Sept 2022 | Bio-Rad
Awesome technology for our lab used for multiple works.
PCR chain reaction
It is appropriate for students. They conduct their research with the help of this product.
Review Date: 24 Aug 2021 | Bio-Rad
Good performance and durable
PCR
Good performance, Veriflex section should be made flexible by avoiding an automated temperature range setting.
Review Date: 25 Jun 2021 | Bio-Rad
Good performance and durable
PCR
Good performance, Veriflex section should be made flexible by avoiding an automated temperature range setting.
Review Date: 25 Jun 2021 | Bio-Rad
I really can not think of another that is as user friendly.
PCR
Its a light small instrument to fit on the bench top of any laboratory. It is very easy to set different programs for different PCR conditions. It is very reliable to use it for reproducibility of my results. This equipment has no maintenance cost. Lasts for a longer time in harsh laboratory environments.
Review Date: 21 Jun 2021 | Bio-Rad
Great purchase.
PCR
It is a user-friendly machine with a good design, especially for gradient temperatures. My lab has never faced any problems with it.
Review Date: 26 Mar 2021 | Bio-Rad
I am loving it!
DNA amplification
Great performance with multiple functions like incubation and amplification. 100% efficiency.
Review Date: 8 Feb 2021 | Bio-Rad
A molecular researcher cannot live without this instrument.
Molecular genetics research: PCR
The use of the tool is very easy and simple. This tool is very important in various molecular studies, especially in my research experience regarding the molecular detection of important genes related to the resistance traits to environmental stress in sugarcane. Maintenance is very easy, so it does not require complicated steps or takes a long time. Prices are quite affordable.
Review Date: 2 Feb 2021 | Bio-Rad
Use the T100 thermal cycler for fast and reliable PCR in a 96-well block format.
- Save time programming with an intuitive touch screen
- Optimize reactions quickly in a single run using thermal gradient technology
- Manage and organize protocols easily using personalized folders
- Save space with the small footprint
Related Products
Use our Thermal Cycler Selection Chart to learn about the complete line of PCR systems Bio-Rad offers.
Recommended Accessories
- Use the touch screen protector to shield the surface of the thermal cycler from dust, reagents, and scratches
- The extra tube support ring allows the use of individual tubes
More Information
Learn more about the T100™ thermal cycler, compatible kits and reagents, and gel systems.
Our Instrument Compatibility Chart lists the range of compatible plastic consumables for all Bio-Rad thermal cyclers.